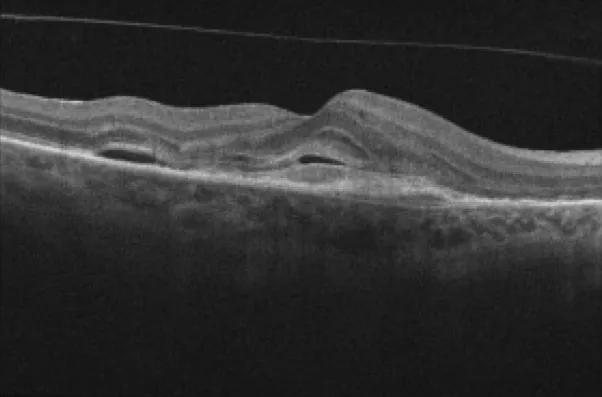

New insights on effectiveness in patients previously treated with other anti-VEGF drugs
Image content: This image is available to view online.
View image online (https://assets.clevelandclinic.org/transform/6b5bf6b9-9888-46dc-97f1-b1840bf5c1ce/oct-scan-nAMD)
Optical coherence tomography image showing macular fluid
High-dose aflibercept (8 mg) may allow for better control of neovascular age-related macular degeneration (nAMD) and less frequent intravitreal injections compared with lower-dose aflibercept (2 mg). However, the dosing schedule recommended by the U.S. Food and Drug Administration (FDA) when it approved the high-dose medication in 2023 poses some restrictions.
Advertisement
Cleveland Clinic is a non-profit academic medical center. Advertising on our site helps support our mission. We do not endorse non-Cleveland Clinic products or services. Policy
The FDA recommends three monthly doses of aflibercept 8 mg and then additional doses, if needed, a minimum of seven weeks apart.
“In my clinic, we have seen some strong results with aflibercept 8 mg, but we also have seen some patients whose maculas don’t completely dry after the initial doses,” says Danny A. Mammo, MD, a vitreoretinal specialist at Cleveland Clinic Cole Eye Institute. “Those patients have needed additional injections maybe five to six weeks apart. That meant we had to switch some of them to other anti-VEGF drugs with less stringent dosing guidelines when their insurers declined to cover the more frequent doses of aflibercept 8 mg.”
To assess this real-world observation, Dr. Mammo and a research team conducted a study on the effectiveness of aflibercept 8 mg in patients at the Cole Eye Institute, including determining the proportion of patients unable to continue extended therapy as outlined by the FDA.
The research study, published in Ophthalmology Retina, involved 219 eyes of Cole Eye Institute patients with nAMD treated with high-dose aflibercept between 2023 and 2024. More than 95% of the patients had been treated previously with other anti-VEGF agents. Most had been treated with aflibercept 2 mg, while others had received faricimab, bevacizumab, ranibizumab or brolucizumab.
Despite having nAMD that was refractory to other treatment, most patients in the study showed reduction in macular fluid as seen on optical coherence tomography:
| At baseline | At final visit | P value | |
|---|---|---|---|
| Mean central subfield thickness | 267.8 µm | 261.4 µm | .356 |
| Mean pigment epithelial detachment height | 203.7 µm (in 207 eyes) | 179.4 µm (in 204 eyes) | .135 |
| Prevalence of intraretinal fluid | 118 eyes (53.9%) | 86 eyes (39.3%) | .002 |
| Prevalence of subretinal fluid | 119 eyes (54.3%) | 90 eyes (41.1%) | .005 |
| Mean central subfield thickness | |||
| At baseline | |||
| 267.8 µm | |||
| At final visit | |||
| 261.4 µm | |||
| P value | |||
| .356 | |||
| Mean pigment epithelial detachment height | |||
| At baseline | |||
| 203.7 µm (in 207 eyes) | |||
| At final visit | |||
| 179.4 µm (in 204 eyes) | |||
| P value | |||
| .135 | |||
| Prevalence of intraretinal fluid | |||
| At baseline | |||
| 118 eyes (53.9%) | |||
| At final visit | |||
| 86 eyes (39.3%) | |||
| P value | |||
| .002 | |||
| Prevalence of subretinal fluid | |||
| At baseline | |||
| 119 eyes (54.3%) | |||
| At final visit | |||
| 90 eyes (41.1%) | |||
| P value | |||
| .005 |
The patients also showed stable best-corrected visual acuity (a mean of 61.9 ETDRS letters before treatment versus 61.7 after treatment). This differs from the results of registration trials CANDELA and PULSAR, in which treatment-naïve patients showed notably improved visual acuity after treatment with high-dose aflibercept.
Advertisement
“Overall, the patients in our study — who had more difficult-to-treat disease — showed improved dryness in their macula and preserved vision after receiving aflibercept 8 mg,” Dr. Mammo says. “However, real-world challenges may limit interval extension in some of these patients.”
Of the eyes studied, 24 (11%) were switched to another therapy after their initial three doses of aflibercept 8 mg. Most (22, 91.6%) were switched due to residual fluid and needing a treatment interval shorter than the minimum seven weeks recommended by the FDA.

Image content: This image is available to view online.
View image online (https://assets.clevelandclinic.org/transform/1f45a288-b88f-4a20-b131-1710247c0476/oct-scan-nAMD-inset)
Macular OCT images of a treatment-naïve patient receiving intravitreal aflibercept 8.0 mg injection. Baseline scan showing intraretinal fluid, subretinal fluid, subretinal hyperreflective material and a pigment epithelial detachment (A). Scan after the three initial doses, with a resolution of both intraretinal fluid and subretinal fluid, allowing the patient to extend the treatment interval beyond seven weeks (B). Recurrence of intraretinal fluid and subretinal fluid after the fifth injection of aflibercept 8.0 mg, requiring a reduction in the treatment interval and a subsequent switch in therapy (C). Resolution of intraretinal fluid and subretinal fluid after treatment with faricimab, administered at four-week intervals (D). Reprinted from Bala et al., Ophthalmol Retina (2025 Feb 7:S2468-6530(25)00054-5), under a Creative Commons CC-BY license.
High-dose aflibercept is a worthwhile medication, able to reduce fluid in nAMD, says Dr. Mammo. It proved safe in the study cohort, with no instances of elevated intraocular pressure or retinal vascular adverse events. However, physicians must pay close attention to the appropriate treatment interval for each patient.
“Many of our previously treated patients were unable to maintain a dry macula at a seven-week interval,” he says. “Some needed to be switched to different medication for more frequent treatment.”
Patients with milder macular edema and shorter disease duration may do better with high-dose aflibercept, he notes. Eyes that were able to sustain the FDA-recommended treatment regimen had fewer previous injections of other anti-VEGF drugs (11.1 injections vs. 25.8 injections) and had lower central subfield thickness at baseline (250.1 µm vs. 272.7 µm), compared with eyes not able to sustain the regimen.
Cole Eye Institute researchers reported similar outcomes in a study of high-dose aflibercept in 100 eyes with diabetic macular edema (DME). Results were presented at the 2025 Association for Research in Vision and Ophthalmology (ARVO) annual meeting. The manuscript is accepted and pending publication.
Advertisement
Aflibercept 8.0 mg demonstrated stable best-corrected visual acuity and significant reduction in central subfield thickness, although 32 eyes (32%) in the cohort could not adhere to a maintenance treatment interval of seven weeks or more, as recommended by the FDA. As a result, 18 eyes were switched to another anti-VEGF agent.
“Aflibercept 8.0 mg preserves function and improves anatomy, although real-world challenges may limit interval extension in both chronic DME and nAMD,” Dr. Mammo says. “Especially in previously treated patients with persistent fluid, a more flexible dosing label or treatments targeting different mechanisms could be helpful.”
Advertisement
Advertisement
Evidence mounts that these diabetes and obesity drugs may protect eyes, not endanger them
CFH gene triggers the eye disease in white patients but not Black patients
A primer on sustained release options
Study explores association between sleep aid and eye disease
Early data show risk is 73% higher in patients with lupus, 40% higher in patients with rheumatoid arthritis
Switching medications may decrease treatment burden and macular fluid
Why retina specialists should get comfortable with this imaging tool
Innovative approach to the procedure can yield significant relief in complex cases